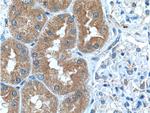
GSS Antibody in Immunohistochemistry (Paraffin) (IHC (P))

Search
Proteintech
GSS Polyclonal Antibody
{{$productOrderCtrl.translations['antibody.pdp.commerceCard.promotion.promotions']}}
{{$productOrderCtrl.translations['antibody.pdp.commerceCard.promotion.viewpromo']}}
{{$productOrderCtrl.translations['antibody.pdp.commerceCard.promotion.promocode']}}: {{promo.promoCode}} {{promo.promoTitle}} {{promo.promoDescription}}. {{$productOrderCtrl.translations['antibody.pdp.commerceCard.promotion.learnmore']}}
产品信息
15712-1-AP
种属反应
已发表种属
宿主/亚型
分类
类型
抗原
偶联物
形式
浓度
规格
纯化类型
保存液
内含物
保存条件
运输条件
产品详细信息
Immunogen sequence: RSDYMFQRS ADGSPALKQI EINTISASFG GLASRTPAVH RHVLSVLSKT KEAGKILSNN PSKGLALGIA KAWELYGSPN ALVLLIAQEK ERNIFDQRAI ENELLARNIH VIRRTFEDIS EKGSLDQDRR LFVDGQEIAV VYFRDGYMPR QYSLQNWEAR LLLERSHAAK CPDIATQLAG TKKVQQELSR PGMLEMLLPG QPEAVARLRA TFAGLYSLDV GEEGDQAIAE ALAAPSRFVL KPQREGGGNN LYGEEMVQAL KQLKDSEERA SYILMEKIEP EPFENCLLRP GSPARVVQCI SELGIFGVYV RQEKTLVMNK HVGHLLRTKA IEHADGGVAA GVAVLDNPYP V (125-474 aa encoded by BC007927)
靶标信息
Glutathione is important for a variety of biological functions, including protection of cells from oxidative damage by free radicals, detoxification of xenobiotics, and membrane transport. The protein encoded by this gene functions as a homodimer to catalyze the second step of glutathione biosynthesis, which is the ATP-dependent conversion of gamma-L-glutamyl-L-cysteine to glutathione. Defects in this gene are a cause of glutathione synthetase deficiency.
仅用于科研。不用于诊断过程。未经明确授权不得转售。
生物信息学
蛋白别名: Glutathione synthase; Glutathione synthetase; GSH S; GSH synthetase; GSH-S; GSHB; MGC14098; OTTHUMP00000030711; unnamed protein product
基因别名: AI314904; CNSHA6; GS-A/GS-B; GSH-S; GSHS; GSS; HEL-S-64p; HEL-S-88n
UniProt ID: (Human) P48637, (Rat) P46413, (Mouse) P51855
Entrez Gene ID: (Human) 2937, (Pig) 100152660, (Dog) 442962, (Rat) 25458, (Mouse) 14854, (Chinese hamster) 100753200